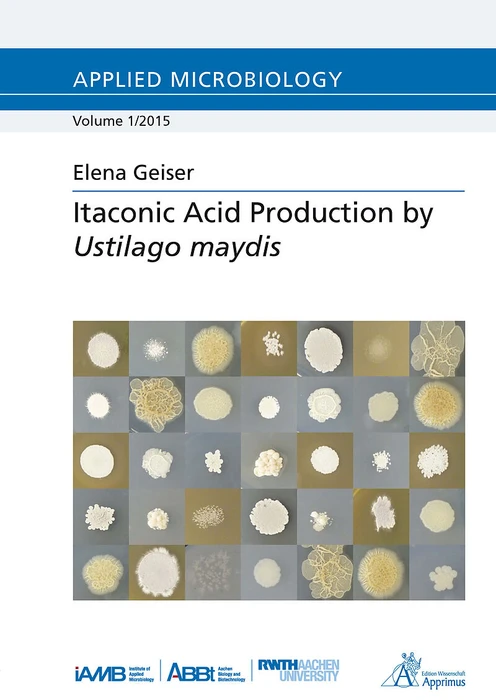

Wir verwenden Cookies und Analyse-Tools, um die Nutzerfreundlichkeit der Internet-Seite zu verbessern und für Marketingzwecke. Wenn Sie fortfahren, diese Seite zu verwenden, nehmen wir an, dass Sie damit einverstanden sind. Zur Datenschutzerklärung.
Itaconic Acid Production by Ustilago maydis
CHF 36.90
Auf Lager
SKU
9O99G3KKKTR
Geliefert zwischen Do., 30.04.2026 und Fr., 01.05.2026
Details
This thesis endorses the establishment of U. maydis as an alternative whole cell biocatalyst for the biosynthesis of itaconate from renewable substrates, such as cellulose or hemicellulose. Therefore, the fungal family Ustilaginaceae was screened for their natural production of value added chemicals, such as itaconate, malate, or succinate, to identify potential novel natural biocatalysts and to find the best producers. The screening was facilitated by the development of a new medium composition (modified Tabuchi medium). In order to combine the utilization of raw biomass components, such as cellulose and hemicellulose, with the production of valuable platform chemicals, such as itaconate, the best itaconate producer, U. maydis MB215, was further characterized towards its xylan degradation ability and itaconate production. A novel biosynthesis pathway for itaconate was identified, including clustered genes encoding the proteins responsible for itaconate production in U. maydis MB215. First metabolic engineering attempts were already successful in enhancing U. maydis' itaconate production two-fold by overexpressing the transcription factor regulating the expression of the itaconate gene cluster. This work lays the foundation for further optimization of U. maydis' itaconate biosynthesis and is therefore a further step towards industrial application of the Ustilaginaceae for the advancement of a sustainable bio-based economy.
Weitere Informationen
- Allgemeine Informationen
- GTIN 09783863593162
- Sprache Englisch
- Genre Biology
- Lesemotiv Verstehen
- Größe H210mm x B8mm x T148mm
- Jahr 2015
- EAN 9783863593162
- Format Fachbuch
- ISBN 978-3-86359-316-2
- Titel Itaconic Acid Production by Ustilago maydis
- Autor Elena Geiser
- Gewicht 293g
- Herausgeber Apprimus Wissenschaftsver
- Anzahl Seiten 154
Bewertungen
Schreiben Sie eine Bewertung